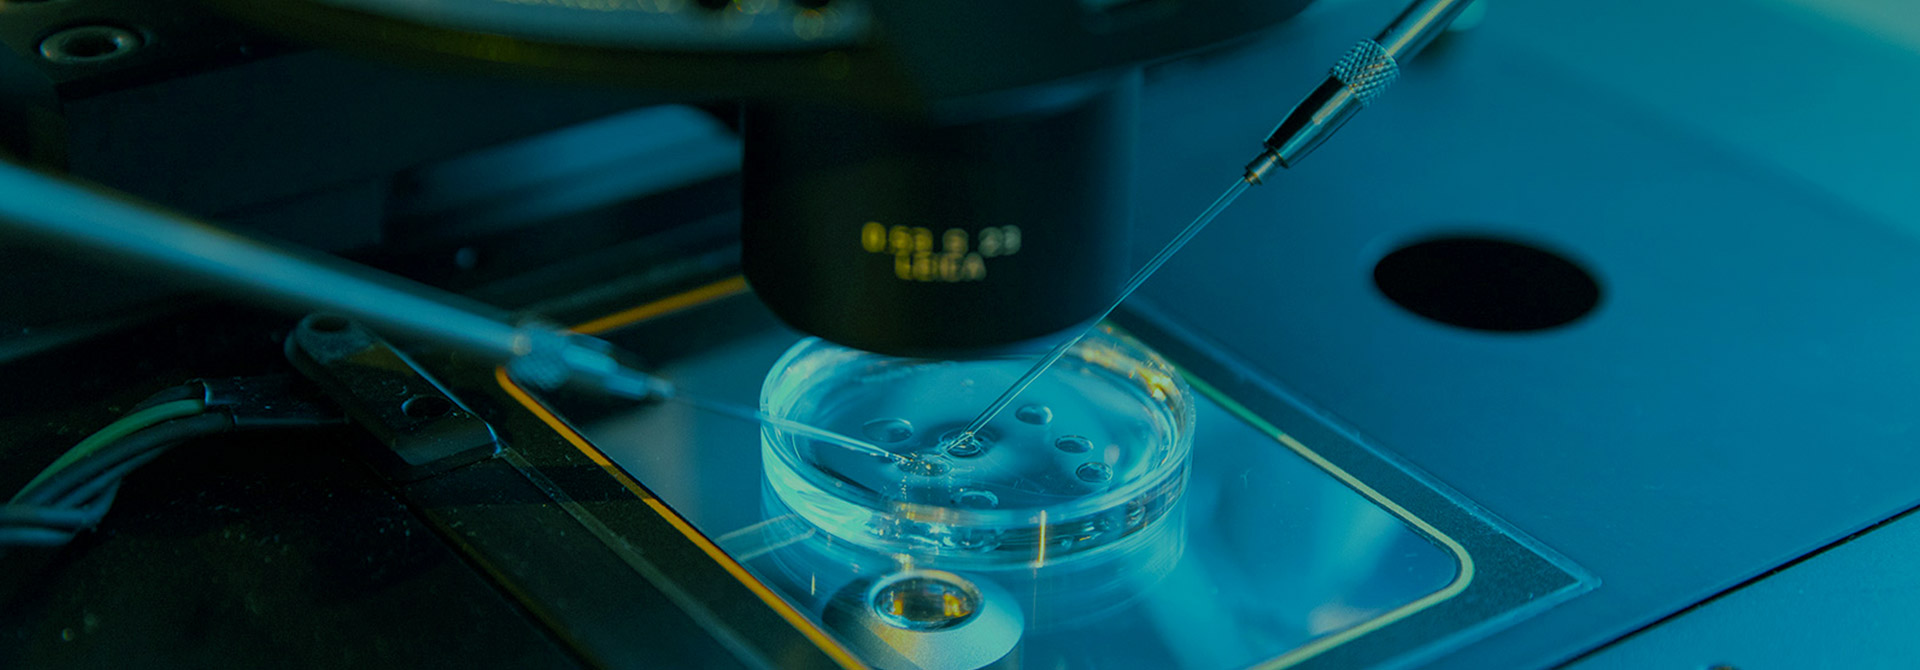

- 首頁
- 關(guān)于中在
-
產(chǎn)品中心
- 高分子材料
- 可降解生物醫(yī)用材料
- 新聞中心
-
加入中在
- 加入中在
- 崗位招聘
- 員工風(fēng)采
- 資料下載
- 聯(lián)系中在
EN

地址:浙江省金華市義烏市北苑街道雪峰西路968號
電話:400-0858-856
郵箱:sales@zjzzyl.com
網(wǎng)址:http://m.zjhpzn.com
Copyright ? 2024 浙江中在醫(yī)療科技有限公司 版權(quán)所有 | 浙ICP備18008633號-1 | 網(wǎng)站地圖 | 藍信云制作維護